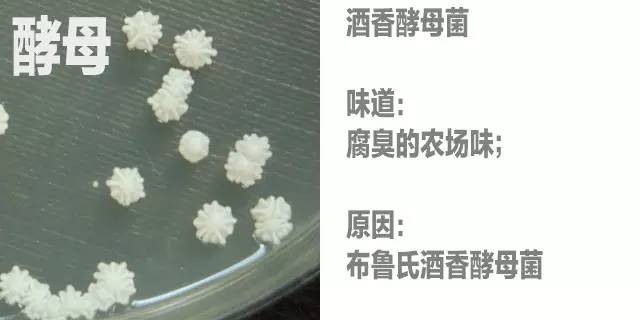

葡萄酒里的独特“风味”?没准因为混进了瓢虫
伦敦一家葡萄酒商店地下,灯光昏暗的酒窖里,一位男士用心嗅着手中的酒杯。他的鼻子深深地探进了杯子,在那一瞬间,就像一座头朝下的冰山,倒栽进夏敦埃(Chardonnay)酒海里。随后,他哼了几声,用笑声打破了那幅画面。带领大家品酒的女士说道:“那样——可不是闻酒香的正确方法。”
等到大家开始掌握品酒的窍门,她便让我们大声喊出自己察觉到的味道。每个人都觉得自己闻到了果香。一位女士说喝出了桉树味,另一位说尝到了燧石味。我们的品酒专家导游表示同意,告诉我们那种矿物般、像燧石一样的味道是夏布利酒(Chablis)的独特属性。她说:“那味道出自葡萄园土壤里的石灰岩。”
夏布利酒何以获得独特味道,这问题背后有个“注定”引人入胜的故事。众多酿酒商在价值2000亿美元的葡萄酒市场中保持各自份额的关键就在于产地的地理、地质和气候条件,以及酿酒工艺——这几项综合起来就是风土(terroir)。正是这些因素赋予了葡萄酒各自独有的风味。葡萄酒的产地也因此成为酿造它们的唯一地点。这一理念形成了全球各种葡萄酒规则的基础,例如香槟酒仅产自法国香槟区。
不过,“风土”这个概念经得起推敲吗?人们最近已经确定了水、土壤、温度、微生物以及人类实践等分别对葡萄酒风味起到的作用,可是渐渐清晰的图景中又浮现出一个问题。如果你可以找出带给名酒那种妙不可言(je ne sais quoi)特性的东西,是不是就可能在别的地方将其仿造出来,也许就在你家花园里的葡萄藤身上?
其实
你尝不出土壤中的矿物质
对风土的最常见看法总是被那些啜饮高级勃艮第葡萄酒的品酒专家和喝着超市廉价葡萄酒的普通人反复提起。英国阿伯里斯特威斯大学(Aberystwyth University)地质学家亚历克斯·马尔特曼(Alex Maltman)表示:“葡萄酒描述中包含各种土壤地址特性,例如花岗岩、石灰石或者某种不为科学所知的特殊成分等,这已经成了标准模版。绝大多数葡萄园声称自己的土壤很特殊并且独一无二。”
近几年,那种矿物般的味道已经有了对应的流行词——“矿石香”(minerality)。
不过,矿物质无法通过任何已知途径从土壤进入葡萄并在其中达到被尝出来的浓度。就算矿物质可以完成这一过程,那它们该是什么味道才对?马尔特曼说:“除了一个奇怪且与此无关的特例——氯化钠——以外,矿物质基本上没什么味道。”
伦敦大学高级研究院(University of London’s School of Advanced Study)的巴里·史密斯(Barry Smith)专门研究味道的多感官知觉。他认为:“那种你能尝出土壤中矿物质的说法就是胡扯。”
不过,这并不代表“矿石香”一词没有意义。史密斯表示,酒在口中引发的感觉可以带给人一种对矿石香的感知。葡萄酒常常被描述带有一种像湿润的石头或干燥的石板一样的味道。史密斯讲道:“如果你舔一下石板,不会觉得有什么味道,但是它的确带给你一种干燥的感觉。”葡萄酒中的丹宁酸会使你觉得口干,可能是这种感觉有时会引发你心中对石板的记忆。也可能是因为你期待尝到石板味,才从酒中找到了一丝石板气息。
“风土”背后的真正因素
风土一案就此告破?还没有:事实是,如果你在不同的地方种植同一种葡萄,得到的葡萄酒在化学成分上确实不一样。去年,法国第戎市勃艮第大学(University of Burgundy)的雷吉斯·古荣(Régis Gougeon)与同事一起运用质谱分析法对比了勃艮第夜丘(Côte de Nuits)地区相隔仅仅2千米的两处地点各自出产的黑皮诺(Pinot Noir)葡萄和葡萄酒。他们发现各个葡萄园出产的葡萄和葡萄酒在脂肪酸、胆固醇、黄酮醇、酚类等物质组成方面迥然不同——这正是风土的化学呈现。
是什么造就了这些差异?一个明显的答案可能是葡萄栽培酿造者的选择不同。葡萄藤如何灌溉、怎样修剪、采摘时间、酵母选用和熟化用桶选择等都会影响最终的味道。可是古荣对比的2个葡萄园由同一个人管理,因此这背后还另有蹊跷。
某些长相思(Sauvignon Blanc)白葡萄酒的标志性味道来自新西兰马尔堡(Marlborough)。葡萄汁中较高的硫醇类物质含量可能与当地的机械采摘有关。
巴塞罗那大学(University of Barcelona)罗莎·拉穆埃拉-雷万托斯(Rosa Lamuela-Raventós)与同事开展的研究提供了一些线索。通过对比西班牙境内条件几近相同地块出产的歌海娜(Grenache)红葡萄,他们发现由较富饶土壤中栽培的葡萄藤上所摘葡萄酿出的酒色泽暗淡,其中酚类芳香化合物含量较低,并且其品质似乎更不易随着熟化过程提高。这可能从某种角度解释了葡萄栽培酿造者的一种普遍看法:若要产好酒,藤蔓必遭罪。
其他一些因素也告诉我们不应该很快抛弃风土概念。土壤以及其他场所中的微生物能影响葡萄酒。俄勒冈州阿什兰市南俄勒冈大学(Southern Oregon University)的格雷格·琼斯(Greg Jones)举了一个著名的例子:菌根真菌与植物根系形成共生关系,帮助植物获得养料。你体内有对自身健康至关重要的微生物菌群,对于葡萄藤而言也是一样,而各个地方有着不同的微生物菌群。
伊利诺伊州勒蒙特市阿贡国家实验室(Argonne National Laboratory)的杰克·吉尔伯特(Jack Gilbert)解释说:“如果你种了一株不带任何微生物的植物,那你肯定酿不出酒。细菌与真菌既影响葡萄的化学成分,也影响葡萄藤的健康。”
特殊储备——“微生物风土”
加利福尼亚大学戴维斯分校(University of California, Davis)的尼古拉斯·伯库里奇(Nickolas Bokulich)与同事一起揭示了葡萄中的“微生物风土”概念。他们的团队发现,用加利福尼亚州不同地区出产的同一种葡萄(他们用了夏敦埃、仙粉黛和赤霞珠等)的鲜榨果汁中微生物组成有明显差别,这种组成还会每年发生变化。不仅如此,同一根葡萄藤的各个部位上,栖居着不同的细菌和真菌群落。
吉尔伯特与同事着手从这些细菌的RNA中寻找植物可能用得上的基因。他们发现葡萄上的细菌含有较多与新陈代谢和化学防御有关的基因(可能是为抵抗饥饿的昆虫),这两类基因均会对味道产生不小影响。葡萄叶、花和果实上的细菌群落则更接近同一植株的土壤菌群,彼此之间的相似度则不大,吉尔伯特由此推测,植物可能会从土壤中寻找不同的微生物,以满足各种特定的需求。吉尔伯特表示,这些微生物群落会因各种因素产生差异,例如土壤pH值。同一个葡萄园中不同垄和不同植株上的微生物群落因此各有差异,更不必提不同葡萄园和不同地区之间的差别了。
那些微生物的影响可能会很大。苏特恩(Sauternes)和托卡伊(Tokaji)等甜葡萄酒只能用那些感染灰葡萄孢菌(Botrytis cinerea,也叫贵霉菌)的葡萄酿成。这种真菌与一种名为土臭素(geosmin)的化合物有关,土臭素可为葡萄酒带来一种泥土味或霉味,有些生活在葡萄果实上的细菌也能如此。
这种真菌使葡萄变得干瘪,甜度变高。例如匈牙利托卡伊葡萄酒中的甜味即由此而来。
在所有微生物中,酵母菌可能是对葡萄酒味道影响最大的群落。酵母菌在发酵过程中把葡萄中的糖分转化为乙醇,同时产生400多种化合物。这些化合物决定了葡萄酒的味道、香气和口感。例如与我一道品酒的女士在她的夏布利酒里尝出了“燧石味”。史密斯解释说:“如果葡萄酒发酵过程中缺乏氧气,酵母菌会产生硫。而只要酒中有一点点硫,你就能闻到火柴味——人们觉得那是燧石味。”
许多葡萄酒酿造者使用的发酵菌是酿酒酵母(Saccharomyces cerevisiae)——啤酒酿造者和面包师用的酵母,以保证味道统一。不过,近些年来有一股潮流,酿酒者开始使用多种自然存在于葡萄园中的酵母菌,以给葡萄酒带来更多风味——更深层次的风土来源。有些人甚至放弃使用杀虫剂,以保护酵母菌。南非斯泰伦博什大学(Stellenbosch University)葡萄酒生物技术研究所的玛莎巴莎·塞塔蒂(Mathabatha Setati)与同事的研究表明,那些人的做法可能有点依据。他们对比了两种葡萄上的酵母菌,一种是依照有机原则运营的葡萄园所出产葡萄,另一种是生长过程中施用传统杀虫剂和肥料的葡萄,在前一种葡萄上发现的酵母菌种类多于在后一种葡萄上发现的。
有些种类的酵母菌已经被确定能为葡萄酒带来与众不同的风味。一种名为布鲁氏酒香酵母(Brettanomyces bruxellensis)的酵母菌只要在酿酒过程的几乎任意阶段被加入,就能为葡萄酒带来一股浓烈的农场气味。绝大多数人觉得这种味道糟蹋了葡萄酒,但是波尔多(Bordeaux)和罗讷(Rhone)的部分酿酒者认为这给他们的葡萄酒增添了独特风格。
这种真菌能在酿酒过程的任何阶段混入。有些酿酒商,比如黎巴嫩的穆萨酒庄(Château Musar),喜欢这种真菌的特点。
甚至你自己身上的微生物都能对味觉产生作用。例如肥胖者唾液中的细菌就会抑制葡萄酒中芳香化合物的释放。你自己本身就是风土的一部分。
在微生物之外,各地不同的气候对葡萄酒味道也起着巨大作用。古荣和同事在去年的研究表明了气候带来的明显差异。他们的研究同时也是为了找到代表风土的化学物质,于是着眼于各年份之间的标志性变化。有趣的是,在他们研究的两块地上同年出产的葡萄酒中化合物组分的近似度,高于同一块地上不同年份所产葡萄酒之间的近似度。随着时间流逝,这种差异还会增加。古荣表示:“葡萄酒对风土的表达,在装瓶后仍然不断成长着,或者说是变化着。”
能影响葡萄酒味道的天气又有什么玄机?温度、降水和日照等因素影响葡萄植株健康、果实生长和成熟速度。它们借此改变了葡萄果实中的化合物组分比例,影响着发酵过程,并决定了什么能进发酵罐,以及酵母菌最终能鼓捣出什么。从整体上看,凉爽气候地区产出的葡萄酒倾向于带有淡雅、清冽的味道,并且酒精度较低,而炎热气候地区出产的葡萄酒味道醇厚,酒精度较高。
气候的影响使许多葡萄栽培者感到前途未卜。葡萄酒典型产地的葡萄生长期平均温度应为12—22℃。但气候变化将在未来几十年内影响全球大部分地区的温度和降水,这自然会改变最适宜某些葡萄种类生长的地区的条件。琼斯问道:“黑皮诺葡萄能在温暖气候下生存吗?很可能不行。它的产地局限于俄勒冈州、华盛顿州、塔斯马尼亚和新西兰等地。这些地区可能会失去那种条件。”
其他著名葡萄产地也可能受影响。琼斯表示:“香槟自带魔力,那是因为产地气候凉爽。较暖的天气会使那种独特味道的呈现变得更为困难。”吉尔伯特认为微生物能帮上忙。只要找到正确的细菌帮手,就能增加植物对气候变化的抵抗力。或者葡萄栽培者得把原有葡萄品种换成适应新条件的其他品种。
你自酿的美乐(Merlot)酒 能有多正宗?
我们到目前为止所讲述的内容还不能解释葡萄酒的所有风味。例如人们很长时间以来一直在思考,为什么有的葡萄酒会带有一丝桉树味?
2013年,澳大利亚葡萄酒研究所(Australian Wine Research Institute)公布了原因,桉树叶与葡萄一起被采摘后堆在一起,在受到挤压时释放出了带有香味的桉树脑化合物。
如果葡萄中混入了桉树叶,它们被压碎后会释放桉树脑。40%澳大利亚红葡萄酒中可检测出桉树脑。
葡萄酒中一种草药般的苦味和气味有时被形容为青椒味,其源头可能是葡萄在收获时混入了瓢虫以及瓢虫释放的甲氧基吡嗪(methoxypyrazines)。
偶然与葡萄一起被压碎的昆虫会释放甲氧基吡嗪。这种化合物曾在2001年导致加拿大葡萄酒酿造者倒掉100万升葡萄酒。
琼斯还表示,葡萄酒的烟味甚至可能是由葡萄带有蜡质的果皮沾染了林火烟尘导致的。
葡萄带有蜡质的果皮能沾染烟尘颗粒,烟尘颗粒中含有愈疮木酚。加利福尼亚州安德森山谷(Anderson Valley)2008年森林大火后出产的很多黑皮诺葡萄酒带有烟味。
不过,我们要回到关键问题上来。既然我们现在能分理出葡萄酒中影响口味的某些成分,那我们能不能复制出带有浆果味、烟味、青椒味和泥土味的1998年产玛歌酒庄(Château Margaux)红酒?你是不是只需要一些赤霞珠葡萄藤、不很热的天气、附近的林火、一把瓢虫和一小撮真菌就够了?
马尔特曼认为,酿造可与名酒媲美的葡萄酒是肯定可行的,许多新大陆葡萄酒(New World wines)的成功已经证明了这一点。不过,除了模仿,你还必须知道所有的变量——有的很难被找出来。吉尔伯特表示:“很多酿酒公司致力于保护自己拥有的风味。如果你发现了他们的微生物群落和葡萄酒之所以那么好的秘密,那他们肯定不会很高兴。”
虽然难说你能轻易复制出波尔多葡萄酒,但是从现有的信息看,你可以一试,而且葡萄酒酿造者都是从尝试开始的。也许是时候找一块地,做一下实验了。至于以后的成果……就顺其自然吧。
等到大家开始掌握品酒的窍门,她便让我们大声喊出自己察觉到的味道。每个人都觉得自己闻到了果香。一位女士说喝出了桉树味,另一位说尝到了燧石味。我们的品酒专家导游表示同意,告诉我们那种矿物般、像燧石一样的味道是夏布利酒(Chablis)的独特属性。她说:“那味道出自葡萄园土壤里的石灰岩。”
夏布利酒何以获得独特味道,这问题背后有个“注定”引人入胜的故事。众多酿酒商在价值2000亿美元的葡萄酒市场中保持各自份额的关键就在于产地的地理、地质和气候条件,以及酿酒工艺——这几项综合起来就是风土(terroir)。正是这些因素赋予了葡萄酒各自独有的风味。葡萄酒的产地也因此成为酿造它们的唯一地点。这一理念形成了全球各种葡萄酒规则的基础,例如香槟酒仅产自法国香槟区。
不过,“风土”这个概念经得起推敲吗?人们最近已经确定了水、土壤、温度、微生物以及人类实践等分别对葡萄酒风味起到的作用,可是渐渐清晰的图景中又浮现出一个问题。如果你可以找出带给名酒那种妙不可言(je ne sais quoi)特性的东西,是不是就可能在别的地方将其仿造出来,也许就在你家花园里的葡萄藤身上?
其实
你尝不出土壤中的矿物质
对风土的最常见看法总是被那些啜饮高级勃艮第葡萄酒的品酒专家和喝着超市廉价葡萄酒的普通人反复提起。英国阿伯里斯特威斯大学(Aberystwyth University)地质学家亚历克斯·马尔特曼(Alex Maltman)表示:“葡萄酒描述中包含各种土壤地址特性,例如花岗岩、石灰石或者某种不为科学所知的特殊成分等,这已经成了标准模版。绝大多数葡萄园声称自己的土壤很特殊并且独一无二。”
近几年,那种矿物般的味道已经有了对应的流行词——“矿石香”(minerality)。
不过,矿物质无法通过任何已知途径从土壤进入葡萄并在其中达到被尝出来的浓度。就算矿物质可以完成这一过程,那它们该是什么味道才对?马尔特曼说:“除了一个奇怪且与此无关的特例——氯化钠——以外,矿物质基本上没什么味道。”
伦敦大学高级研究院(University of London’s School of Advanced Study)的巴里·史密斯(Barry Smith)专门研究味道的多感官知觉。他认为:“那种你能尝出土壤中矿物质的说法就是胡扯。”
不过,这并不代表“矿石香”一词没有意义。史密斯表示,酒在口中引发的感觉可以带给人一种对矿石香的感知。葡萄酒常常被描述带有一种像湿润的石头或干燥的石板一样的味道。史密斯讲道:“如果你舔一下石板,不会觉得有什么味道,但是它的确带给你一种干燥的感觉。”葡萄酒中的丹宁酸会使你觉得口干,可能是这种感觉有时会引发你心中对石板的记忆。也可能是因为你期待尝到石板味,才从酒中找到了一丝石板气息。
“风土”背后的真正因素
风土一案就此告破?还没有:事实是,如果你在不同的地方种植同一种葡萄,得到的葡萄酒在化学成分上确实不一样。去年,法国第戎市勃艮第大学(University of Burgundy)的雷吉斯·古荣(Régis Gougeon)与同事一起运用质谱分析法对比了勃艮第夜丘(Côte de Nuits)地区相隔仅仅2千米的两处地点各自出产的黑皮诺(Pinot Noir)葡萄和葡萄酒。他们发现各个葡萄园出产的葡萄和葡萄酒在脂肪酸、胆固醇、黄酮醇、酚类等物质组成方面迥然不同——这正是风土的化学呈现。
是什么造就了这些差异?一个明显的答案可能是葡萄栽培酿造者的选择不同。葡萄藤如何灌溉、怎样修剪、采摘时间、酵母选用和熟化用桶选择等都会影响最终的味道。可是古荣对比的2个葡萄园由同一个人管理,因此这背后还另有蹊跷。
某些长相思(Sauvignon Blanc)白葡萄酒的标志性味道来自新西兰马尔堡(Marlborough)。葡萄汁中较高的硫醇类物质含量可能与当地的机械采摘有关。
巴塞罗那大学(University of Barcelona)罗莎·拉穆埃拉-雷万托斯(Rosa Lamuela-Raventós)与同事开展的研究提供了一些线索。通过对比西班牙境内条件几近相同地块出产的歌海娜(Grenache)红葡萄,他们发现由较富饶土壤中栽培的葡萄藤上所摘葡萄酿出的酒色泽暗淡,其中酚类芳香化合物含量较低,并且其品质似乎更不易随着熟化过程提高。这可能从某种角度解释了葡萄栽培酿造者的一种普遍看法:若要产好酒,藤蔓必遭罪。
其他一些因素也告诉我们不应该很快抛弃风土概念。土壤以及其他场所中的微生物能影响葡萄酒。俄勒冈州阿什兰市南俄勒冈大学(Southern Oregon University)的格雷格·琼斯(Greg Jones)举了一个著名的例子:菌根真菌与植物根系形成共生关系,帮助植物获得养料。你体内有对自身健康至关重要的微生物菌群,对于葡萄藤而言也是一样,而各个地方有着不同的微生物菌群。
伊利诺伊州勒蒙特市阿贡国家实验室(Argonne National Laboratory)的杰克·吉尔伯特(Jack Gilbert)解释说:“如果你种了一株不带任何微生物的植物,那你肯定酿不出酒。细菌与真菌既影响葡萄的化学成分,也影响葡萄藤的健康。”
特殊储备——“微生物风土”
加利福尼亚大学戴维斯分校(University of California, Davis)的尼古拉斯·伯库里奇(Nickolas Bokulich)与同事一起揭示了葡萄中的“微生物风土”概念。他们的团队发现,用加利福尼亚州不同地区出产的同一种葡萄(他们用了夏敦埃、仙粉黛和赤霞珠等)的鲜榨果汁中微生物组成有明显差别,这种组成还会每年发生变化。不仅如此,同一根葡萄藤的各个部位上,栖居着不同的细菌和真菌群落。
吉尔伯特与同事着手从这些细菌的RNA中寻找植物可能用得上的基因。他们发现葡萄上的细菌含有较多与新陈代谢和化学防御有关的基因(可能是为抵抗饥饿的昆虫),这两类基因均会对味道产生不小影响。葡萄叶、花和果实上的细菌群落则更接近同一植株的土壤菌群,彼此之间的相似度则不大,吉尔伯特由此推测,植物可能会从土壤中寻找不同的微生物,以满足各种特定的需求。吉尔伯特表示,这些微生物群落会因各种因素产生差异,例如土壤pH值。同一个葡萄园中不同垄和不同植株上的微生物群落因此各有差异,更不必提不同葡萄园和不同地区之间的差别了。
那些微生物的影响可能会很大。苏特恩(Sauternes)和托卡伊(Tokaji)等甜葡萄酒只能用那些感染灰葡萄孢菌(Botrytis cinerea,也叫贵霉菌)的葡萄酿成。这种真菌与一种名为土臭素(geosmin)的化合物有关,土臭素可为葡萄酒带来一种泥土味或霉味,有些生活在葡萄果实上的细菌也能如此。
这种真菌使葡萄变得干瘪,甜度变高。例如匈牙利托卡伊葡萄酒中的甜味即由此而来。
在所有微生物中,酵母菌可能是对葡萄酒味道影响最大的群落。酵母菌在发酵过程中把葡萄中的糖分转化为乙醇,同时产生400多种化合物。这些化合物决定了葡萄酒的味道、香气和口感。例如与我一道品酒的女士在她的夏布利酒里尝出了“燧石味”。史密斯解释说:“如果葡萄酒发酵过程中缺乏氧气,酵母菌会产生硫。而只要酒中有一点点硫,你就能闻到火柴味——人们觉得那是燧石味。”
许多葡萄酒酿造者使用的发酵菌是酿酒酵母(Saccharomyces cerevisiae)——啤酒酿造者和面包师用的酵母,以保证味道统一。不过,近些年来有一股潮流,酿酒者开始使用多种自然存在于葡萄园中的酵母菌,以给葡萄酒带来更多风味——更深层次的风土来源。有些人甚至放弃使用杀虫剂,以保护酵母菌。南非斯泰伦博什大学(Stellenbosch University)葡萄酒生物技术研究所的玛莎巴莎·塞塔蒂(Mathabatha Setati)与同事的研究表明,那些人的做法可能有点依据。他们对比了两种葡萄上的酵母菌,一种是依照有机原则运营的葡萄园所出产葡萄,另一种是生长过程中施用传统杀虫剂和肥料的葡萄,在前一种葡萄上发现的酵母菌种类多于在后一种葡萄上发现的。
有些种类的酵母菌已经被确定能为葡萄酒带来与众不同的风味。一种名为布鲁氏酒香酵母(Brettanomyces bruxellensis)的酵母菌只要在酿酒过程的几乎任意阶段被加入,就能为葡萄酒带来一股浓烈的农场气味。绝大多数人觉得这种味道糟蹋了葡萄酒,但是波尔多(Bordeaux)和罗讷(Rhone)的部分酿酒者认为这给他们的葡萄酒增添了独特风格。
这种真菌能在酿酒过程的任何阶段混入。有些酿酒商,比如黎巴嫩的穆萨酒庄(Château Musar),喜欢这种真菌的特点。
甚至你自己身上的微生物都能对味觉产生作用。例如肥胖者唾液中的细菌就会抑制葡萄酒中芳香化合物的释放。你自己本身就是风土的一部分。
在微生物之外,各地不同的气候对葡萄酒味道也起着巨大作用。古荣和同事在去年的研究表明了气候带来的明显差异。他们的研究同时也是为了找到代表风土的化学物质,于是着眼于各年份之间的标志性变化。有趣的是,在他们研究的两块地上同年出产的葡萄酒中化合物组分的近似度,高于同一块地上不同年份所产葡萄酒之间的近似度。随着时间流逝,这种差异还会增加。古荣表示:“葡萄酒对风土的表达,在装瓶后仍然不断成长着,或者说是变化着。”
能影响葡萄酒味道的天气又有什么玄机?温度、降水和日照等因素影响葡萄植株健康、果实生长和成熟速度。它们借此改变了葡萄果实中的化合物组分比例,影响着发酵过程,并决定了什么能进发酵罐,以及酵母菌最终能鼓捣出什么。从整体上看,凉爽气候地区产出的葡萄酒倾向于带有淡雅、清冽的味道,并且酒精度较低,而炎热气候地区出产的葡萄酒味道醇厚,酒精度较高。
气候的影响使许多葡萄栽培者感到前途未卜。葡萄酒典型产地的葡萄生长期平均温度应为12—22℃。但气候变化将在未来几十年内影响全球大部分地区的温度和降水,这自然会改变最适宜某些葡萄种类生长的地区的条件。琼斯问道:“黑皮诺葡萄能在温暖气候下生存吗?很可能不行。它的产地局限于俄勒冈州、华盛顿州、塔斯马尼亚和新西兰等地。这些地区可能会失去那种条件。”
其他著名葡萄产地也可能受影响。琼斯表示:“香槟自带魔力,那是因为产地气候凉爽。较暖的天气会使那种独特味道的呈现变得更为困难。”吉尔伯特认为微生物能帮上忙。只要找到正确的细菌帮手,就能增加植物对气候变化的抵抗力。或者葡萄栽培者得把原有葡萄品种换成适应新条件的其他品种。
你自酿的美乐(Merlot)酒 能有多正宗?
我们到目前为止所讲述的内容还不能解释葡萄酒的所有风味。例如人们很长时间以来一直在思考,为什么有的葡萄酒会带有一丝桉树味?
2013年,澳大利亚葡萄酒研究所(Australian Wine Research Institute)公布了原因,桉树叶与葡萄一起被采摘后堆在一起,在受到挤压时释放出了带有香味的桉树脑化合物。
如果葡萄中混入了桉树叶,它们被压碎后会释放桉树脑。40%澳大利亚红葡萄酒中可检测出桉树脑。
葡萄酒中一种草药般的苦味和气味有时被形容为青椒味,其源头可能是葡萄在收获时混入了瓢虫以及瓢虫释放的甲氧基吡嗪(methoxypyrazines)。
偶然与葡萄一起被压碎的昆虫会释放甲氧基吡嗪。这种化合物曾在2001年导致加拿大葡萄酒酿造者倒掉100万升葡萄酒。
琼斯还表示,葡萄酒的烟味甚至可能是由葡萄带有蜡质的果皮沾染了林火烟尘导致的。
葡萄带有蜡质的果皮能沾染烟尘颗粒,烟尘颗粒中含有愈疮木酚。加利福尼亚州安德森山谷(Anderson Valley)2008年森林大火后出产的很多黑皮诺葡萄酒带有烟味。
不过,我们要回到关键问题上来。既然我们现在能分理出葡萄酒中影响口味的某些成分,那我们能不能复制出带有浆果味、烟味、青椒味和泥土味的1998年产玛歌酒庄(Château Margaux)红酒?你是不是只需要一些赤霞珠葡萄藤、不很热的天气、附近的林火、一把瓢虫和一小撮真菌就够了?
马尔特曼认为,酿造可与名酒媲美的葡萄酒是肯定可行的,许多新大陆葡萄酒(New World wines)的成功已经证明了这一点。不过,除了模仿,你还必须知道所有的变量——有的很难被找出来。吉尔伯特表示:“很多酿酒公司致力于保护自己拥有的风味。如果你发现了他们的微生物群落和葡萄酒之所以那么好的秘密,那他们肯定不会很高兴。”
虽然难说你能轻易复制出波尔多葡萄酒,但是从现有的信息看,你可以一试,而且葡萄酒酿造者都是从尝试开始的。也许是时候找一块地,做一下实验了。至于以后的成果……就顺其自然吧。

0 个回复